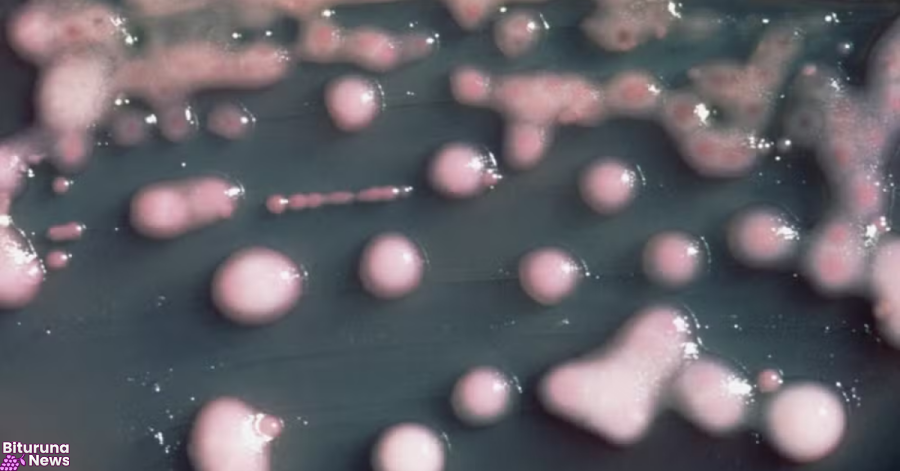
Fauna silvestre pode indicar avanço de superbactérias fora de hospitais, diz pesquisa

Tempo Hoje
° | °
° | °Últimas Notícias
- Nova previsão de geada e termômetros a 0ºC no Sul do Paraná na próxima semana
- Erro ao usar bombinha para asma pode anular o efeito do remédio; veja como fazer certo
- Gripe pode ser grave em crianças, mas vacinação no Paraná está muito baixa
- Mega-Sena sorteia prêmio acumulado em R$ 8 milhões nesta terça-feira
- Produção de carvão ilegal em Inácio Martins dá multa de R$ 50 mil e um preso
- Em São Mateus do Sul, PM prende homem com 367 gramas de maconha durante patrulhamento
- Três mandados de prisão são cumpridos em um só dia em União da Vitória e General Carneiro
- Autor de feminicídio em Palmas se apresenta à polícia e é preso; vítima foi morta com o filho no colo
- Jovem de 24 anos é morta a tiros pelo companheiro em Imbituva; ele confessou ciúmes e foi preso 12 horas depois
- Sinais de inverno: maio terá frentes frias, geada e temperaturas abaixo de 10°C